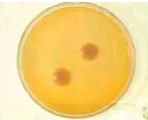
生物玻片

酵母菌是一群單細胞的真核微生物。通常用于以芽殖或裂殖來進行無性繁殖,有些可產生子囊孢子進行有性繁殖。
喜歡在含糖量高、偏酸性的環境中生長。
一、酵母菌的形狀、大小
基本特征:單細胞;橢圓形、圓形或柱形。
寬1-5um,長5-30um。
特殊形態:假菌絲
假菌絲是由酵母菌細胞與其子細胞連接而成的鏈狀絲。
二、酵母菌的繁殖方式
無性繁殖
芽殖
細胞表面的芽細胞發育成熟,脫離母細胞形成子細胞的過程。
三、酵母菌的菌落特征
菌落特征:
表面濕潤,粉粒狀、粗糙、粘稠等,易被提取,較細菌大而厚,培養時間長呈皺縮壯、較干燥,通常帶有乳白色、紅色等顏色。
四、酵母菌的代表
(一)釀酒酵母
(二)產朊假絲酵母(水處理等)
五、酵母的運用
1.酵母幫助人類將面粉發酵,才有了全人類的主食——面包、饅頭等;
2.酵母將糖類物質轉化成食用酒精,才有了美味的葡萄酒、威士忌、中國白酒
酵母把自己的內涵物質轉化成人類青睞的鮮味劑——酵母抽提物,還把細胞壁分解成葡聚糖,奉獻給人們食用和醫用;
3.酵母幫助養殖業增強動物機體免疫功能,促進人類食物安全和營養健康;
4.在發現微量元素是人類不可或缺營養的的當下,酵母將無機微量元素吸收體內,創造了安全、天然的生物態微量元素補充劑,幫助人類預防疾病、延年益壽。如酵母鋅、酵母硒、酵母鉻等。
新鄉市維克科教儀器有限公司主營產品包括:生物切片標本、植物標本、蓋玻片、組胚病理切片、顯微鏡切片、彩色切片套裝、植物浸制標本,顯微鏡生物玻片等科教產品。產品因其制作精良,質量卓越,在業界備受贊譽,詳情請咨詢:0373-5128357